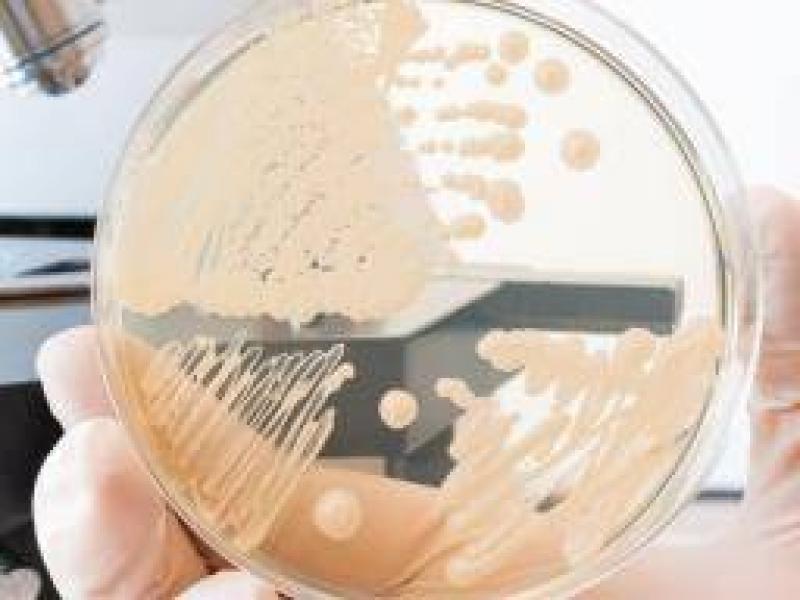

Vajinal bakteriyoz olarak da bilinen bakteriyel vajinoz, çocuk doğurma çağındaki kadınlar için en yaygın vajinal enfeksiyon nedenidir.
Sıklıkla yeni bir eşle cinsel ilişkiden sonra gelişir ve bir kadının hiç cinsel ilişkiye girmemiş olması nadirdir.
Bakteriyel vajinoz (BV) ayrıca cinsel yolla bulaşan bir enfeksiyon (CYBE) geliştirme riskini arttırır. Bununla birlikte, BV bir STI olarak kabul edilmez.
BV, 15 ila 44 yaş arasındaki kadınları etkileme olasılığı en yüksek vajinal enfeksiyondur.
Bakteriyel vajinit hakkında
- Bakteriyel vajinit (BV), 15 ila 44 yaşları arasındaki kadınlar arasında en yaygın vajinal enfeksiyondur.
- Belirtiler, ortaya çıkarsa, kaşıntı ve "balık" kokusu ile gri, sulu akıntı içerebilir.
- Tedavi edilmeyen BV ciddi komplikasyonlara neden olabilir.
- Tedavi normalde antibiyotik ile yapılır .
- Bazı ev ilaçları önerilmektedir, ancak belirtileri olan herkes doktora görünmelidir.
Bakteriyel vajinoz belirtileri
BV semptomlar olmadan mevcut olabilir, ancak semptomlar ortaya çıkarsa, vajinal akıntı, yanma ve kaşıntı içerir.
Vajinal akıntı olabilir:
- sulu ve zayıf
- gri veya beyaz renkli
- genellikle balık olarak tanımlanan güçlü ve nahoş bir kokuya sahip olmak
Daha az yaygın olarak:
- idrar yaparken yanma hissi
- vajinanın dışına kaşıntı
BV'li kadınların yüzde 50 ila 75'inde hiçbir belirti yoktur. Sadece BV'nin zararlı olduğu düşünülmemektedir, ancak komplikasyonlar ortaya çıkabilir.
Komplikasyonlar
BV ile bağlantılı komplikasyonlar arasında daha yüksek riskler vardır:
- BV, virüse duyarlılığı arttırdığından HIV enfeksiyonu
- Uçuk simpleks virüsü, klamidya , bel soğukluğu ve insan papilloma virüsü ( HPV ) gibi CYBE
- ameliyat sonrası enfeksiyon, örneğin, bir sonlandırma veya histerektomi sonrası
BV'nin hamilelik sırasındaki olası komplikasyonları şunlardır:
- erken doğum
- hamilelik kaybı
- amniyotik kese çok erken açılması
- doğum sonrası endometrit, doğumdan sonra uterus zarının tahrişi veya iltihabı
- yumurtalıkları uterusa bağlayan fallop tüplerinin hasar görmesinden kaynaklanan tubal faktör kısırlığı
- korionamniyonit, fetüsün çevresindeki zarların iltihabı, koryon ve amniyon olarak bilinir
Korioamniyonit erken doğum şansını önemli ölçüde artırır. Yenidoğan hayatta kalırsa, beyin felci riski daha yüksektir.
Bir kadının BV olması durumunda, in vitro fertilizasyonun (IVF) başarılı olması daha düşük olabilir.
BV ayrıca, infertilite dahil olmak üzere ciddi sonuçları olabilecek üst kadın genital yolunun bir enfeksiyonu ve enflamasyonu olan pelvik inflamatuar hastalık (PID) riskini de arttırmaktadır.
Nedenler
BV, bir kadının vajinasında bulunan normal bakteriler olan doğal olarak oluşan bakteri florasının dengesizliğinden kaynaklanır. Bunun neden olduğu belli değil.
Kandidiyazis , bir mantar enfeksiyonu veya Trichomonas vaginalis (T. vaginalis) veya trichomoniasis'ten farklı olarak triko olarak bilinir. Bunlara bakteri neden olmaz
Bakterilerin rolü
Vücudun tüm bölümlerinde bakteri bulunur, ancak bazıları zararlı iken bazıları yararlıdır. Çok fazla zararlı bakteri olduğunda, sorunlar ortaya çıkabilir.
Vajina çoğunlukla "iyi" bakteri ve bazı zararlı bakteri içerir. BV, zararlı bakteriler sayıca çoğaldığında ortaya çıkar.
Bir vajina, laktobasil adı verilen bakteri içermelidir. Bu bakteriler laktik asit üreterek vajinayı hafif asidik hale getirir. Bu, diğer bakterilerin orada büyümesini önler.
Düşük laktobasilli seviyeleri vajinanın daha az asitli olmasına neden olabilir. Vajina olması gerektiği kadar asidik değilse, bu diğer bakterilere büyüme ve gelişme şansını verebilir. Ancak, bu zararlı bakterilerin BV ile nasıl bağlantılı olduğu tam olarak bilinmemektedir.
Risk faktörleri
Herhangi bir kadın BV'yi geliştirebilir, ancak bazı davranışlar veya faaliyetler riski artırabilir.
Bunlar şunları içerir:
- vajinayı temizlemek için duş veya su veya ilaçlı bir çözelti kullanmak
- antiseptik sıvılarla banyo yapmak
- yeni bir seks partneri olmak
- birden fazla seks partnere sahip olmak
- parfümlü köpük banyoları, vajinal deodorantlar ve bazı kokulu sabunlar kullanarak
- sigara içmek
- Güçlü deterjanlı çamaşırlar
BV tuvalet koltuklarından, yatak takımlarından, yüzme havuzlarından veya dokunma nesnelerinden yakalanamaz.
Bakteriyel vajinoz tedavisi
BV genellikle tedavi görmeden temizlenir, ancak belirti ve semptomları olan kadınlar komplikasyonları önlemek için tedavi aramalıdır.
Semptom yoksa tedavi gerekmeyebilir. Bazen BV görünürde bir sebep olmadan ortaya çıkabilir ve yok olabilir.
Anormal vajinal akıntı varsa, bir doktora en kısa zamanda bakmak önemlidir. Doktorlar BV'yi teşhis edebilir ve bel soğukluğu veya triko gibi diğer enfeksiyonları ekarte edebilir.
Tedavi edilmeyen BV ayrıca özellikle hamilelik sırasında komplikasyonlara yol açabilir. Bazı doktorlar, semptomlara bakılmaksızın, işlemden önce histerektomi veya sonlandırma geçirecek olan tüm kadınlara BV tedavisi önermektedir.
Erkek partnerler genellikle tedaviye ihtiyaç duymazlar, ancak BV'yi kadın seks partnerleri arasında yayabilirler.
Antibiyotik ilaç
Antibiyotikler kadar etkilidir
Metronidazol BV için en yaygın antibiyotiktir.
Aşağıdaki şekillerde mevcuttur:
- Tabletler: 7 gün boyunca günde iki kez ağızdan alınır. Kadın emziriyorsa veya hamile ise en etkili tedavi ve tercih edilen tedavi olarak görülür.
- Tek bir tablet: Bir kerelik doz olarak ağızdan alınır. BV'nin 7 günlük tablet kursu ile karşılaştırıldığında, bu tedaviyle geri dönme olasılığı daha yüksektir.
- Jel: Vajinaya 5 gün süreyle günde bir kez uygulanır.
Metronidazol alkol ile reaksiyona girer. Kombinasyon hastanın çok hasta hissetmesine neden olabilir. Metronidazol alan bireyler daha sonra en az 48 saat boyunca alkol tüketmemelidir.
Klindamisin alternatif bir antibiyotiktir. Metronidazol etkili değilse veya enfeksiyon tekrar ederse kullanılabilir.
Klindamisin kullanırken, lateks prezervatif, diyafram ve kapak gibi bariyer kontrasepsiyon yöntemleri daha az etkili olabilir.
Tinidazol , bazen metronidazol çalışmadığında veya BV tekrar ederse BV'yi tedavi etmek için kullanılan başka bir antibiyotiktir. Tek bir doz olarak ağızdan alınır. Bu ilacı alırken alkolden uzak durulmalıdır.
Aşağıdakiler gerçekleşirse, daha fazla test yapılması gerekecektir:
- belirtiler devam ediyor
- belirtiler gider ama geri gelir
- hasta hamile
Bir antibiyotik tedavisi tamamlandıktan sonra semptomlar düzelirse, kadının tekrar BV için test edilmesi gerekmez.
Tekrarlayan semptomlar
Semptomları tedavi ile kaybolan kadınların yaklaşık yüzde 30'u 3 ay içerisinde nüks edecekti ve yüzde 50'si 6 ay içinde tekrar edecek.
Bu, 7 günlük oral veya vajinal metronidazol veya klindamisin ile tedavi edilebilir. Eğer önceki tedavi ağızdan yapılmışsa, ikinci kez vajinal tedavi daha iyi sonuç verebilir ve ilk tedavi vajinal ise takip tedavisi ağızdan yapılmalıdır.
Eğer 12 ay içerisinde üçten fazla atak olursa, doktor haftada iki ila 3 ay kullanmak için vajinal bir metronidazol jel reçete edebilir.
Bakteriyel vajinoz teşhisi
Doktor BV'yi semptomların tanımından ve fiziksel muayeneden teşhis edebilir. Hoş olmayan bir koku ve ince, beyaz veya gri akıntılara dikkat ederler.
Hasta cinsel olarak aktifse ve bir CYBE olma ihtimali varsa, doktor bazı tanı testleri isteyebilir.
Örnek hücreleri vajinal duvardan toplamak için bir çubuk veya küçük plastik halka kullanılabilir. Asitlik seviyelerini değerlendirmek için vajinanın pH dengesi de ölçülebilir.
Evde uygulanan tedaviler
BV için reçetesiz ilaç tedavisi onaylanmamıştır, ancak probiyotiklerin BV tedavisine yardımcı olabileceği konusunda kanıtlar yoktur.
Ocak 2014'te yayınlanan çalışmaların bir incelemesi şu sonuca varıyor:
“Farklı çalışmaların sonuçları tartışmalı olsa da, çoğu çalışma BV'nin önlenmesi veya tedavisinde probiyotiklerin lehine olmuştur ve herhangi bir olumsuz etki bildirilmemiştir.
Bu nedenle, kadınlar arasında halk sağlığını iyileştirmek için günlük probiyotik ürünlerin tüketimini önermek faydalı olabilir. ”
Bununla birlikte, etkinliğini doğrulamak için daha fazla araştırmaya ihtiyaç vardır.
Diğer bazı ev ilaçları önerilmiştir, ancak BV ciddi komplikasyonlara yol açabileceğinden, semptomları olan herkes bir doktora görünmelidir.
Önleme ipuçları
Kesin nedenler belirsiz kaldığından BV'yi önlemenin kesin bir yolu yoktur. Bununla birlikte, bazı ipuçları bunu önlemeye yardımcı olabilir.
Bunlar şunları içerir:
- güvenli seks yapmak
- dokunma
Hastalık Kontrol ve Önleme Merkezleri (CDC), BV’nin